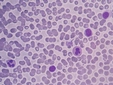
İdrarda Maya Hücresi Nedir ve Faydaları Nelerdir? İdrarda Maya Hücresi Nedir ve Faydaları Nelerdir?

Saprofit bakteriler hücre dışı sindirimi nasıl gerçekleştirir?
Saprofit bakteriler, organik maddeleri parçalayan ve ekosistemlerde önemli roller üstlenen mikroorganizmalardır. Hücre dışı sindirim mekanizmaları sayesinde besin döngülerine katkı sağlarlar. Bu süreçler, toprak verimliliğini artırarak bitkilerin büyümesi için gerekli besin maddelerini temin eder.
Saprofit Bakteriler Hücre Dışı Sindirimi Nasıl Gerçekleştirir?Saprofit bakteriler, organik maddeleri parçalayarak enerji elde eden ve çevrelerinde bulunan ölü organik materyal üzerinde yaşayan mikroorganizmalardır. Bu bakteriler, ekosistemlerde önemli bir rol oynamaktadırlar ve çeşitli besin döngülerinin işleyişinde kritik bir fonksiyon üstlenmektedirler. Saprofit bakterilerin hücre dışı sindirimi, bu organizmaların hayatta kalabilmesi ve büyüyebilmesi için gerekli olan besin maddelerini elde etme sürecinde temel bir mekanizmadır. Saprofit Bakterilerin Temel Özellikleri Saprofit bakterilerin özellikleri, onların beslenme biçimi ve çevreleriyle olan etkileşimleri açısından büyük önem taşır. Bu özellikler şunlardır:
Hücre Dışı Sindirim Süreci Saprofit bakteriler, hücre dışı sindirim sürecini aşağıdaki aşamalarla gerçekleştirirler:
Ekosistemlerdeki Rolü Saprofit bakterilerin ekosistemlerdeki rolü oldukça önemlidir. Bu bakteriler, organik materyalin geri dönüşümünü sağlarken, toprak verimliliğini artırmakta ve diğer canlıların yaşam döngülerine katkıda bulunmaktadır. Ayrıca, bu bakterilerin faaliyetleri sayesinde, toprağın mineral içeriği zenginleşir ve bitkilerin büyümesi için gerekli olan besin maddeleri sağlanmış olur. Sonuç Saprofit bakteriler, hücre dışı sindirim mekanizmaları sayesinde organik maddeleri parçalayarak ekosistemlerdeki besin döngüsünün devamlılığını sağlarlar. Bu süreçte enzim üretimi ve moleküler parçalanma gibi önemli aşamalar yer alır. Saprofit bakterilerin varlığı, doğal ekosistemlerin sağlıklı işleyişi açısından hayati bir öneme sahiptir. Dolayısıyla, bu mikroorganizmaların biyolojik çeşitlilik içindeki yerleri ve fonksiyonları, çevre bilimleri ve ekoloji çalışmaları açısından dikkatle incelenmesi gereken bir konudur. |

Saprofit bakterilerin hücre dışı sindirim sürecinin nasıl işlediğini öğrenmek gerçekten ilginç. Bu bakterilerin, çevrelerinde bulunan organik maddeleri parçalayıp enerji elde etmesi, ekosistemler için kritik bir rol oynuyor. Enzim salgılayarak organik maddeleri küçük bileşenlere ayırmaları, besin döngüsünün sürdürülebilirliği açısından oldukça önemli. Bu bakterilerin çeşitliliği ve farklı türlerde organik maddeleri sindirme yetenekleri, doğadaki dengeyi sağlamakta büyük bir etki yaratıyor. Peki, bu süreçlerin doğadaki diğer canlılarla ilişkisini düşündüğümüzde, saprofit bakterilerin ekosistemlerdeki işlevleri hakkında daha fazla bilgi edinmek, bu mikroorganizmaların önemini daha iyi anlamamıza yardımcı olabilir mi?
Saprofit Bakterilerin Önemi
İsrâc, saprofit bakterilerin ekosistemler üzerindeki etkisi gerçekten de hayranlık verici. Bu bakterilerin organik maddeleri parçalayarak enerji elde etmesi, doğadaki besin döngüsünün temel taşlarından birini oluşturuyor. Bu süreç, hem çevre temizliği hem de besin zincirinin sürdürülebilirliği açısından kritik bir rol oynuyor.
Enzim Salgılama Süreci
Bu bakterilerin enzim salgılayarak organik maddeleri daha küçük bileşenlere ayırması, diğer canlıların bu maddelerden faydalanabilmesi için önemli bir aşama. Bu sayede, bitkiler ve diğer canlılar, ihtiyaç duydukları besin maddelerine erişebiliyor. Böylece, doğadaki denge korunuyor ve ekosistemler sağlıklı bir şekilde işleyebiliyor.
Mikroorganizmaların Rolü
Saprofit bakterilerin çeşitliliği, farklı türlerin organik maddeleri sindirme yetenekleri, ekosistemlerdeki işlevlerini daha da güçlendiriyor. Bu durum, sadece mikroorganizmaların değil, aynı zamanda bitkiler, hayvanlar ve diğer canlıların yaşam döngüleri üzerinde de doğrudan etkili. Dolayısıyla, saprofit bakterilerin ekosistemlerdeki rolünü anlamak, doğanın karmaşık ilişkilerini daha iyi kavramamıza yardımcı oluyor.
Sonuç olarak, saprofit bakterilerin işlevleri hakkında daha fazla bilgi edinmek, ekosistemlerin dengesini koruma ve biyolojik çeşitliliği anlama açısından önemli bir adım olacaktır.